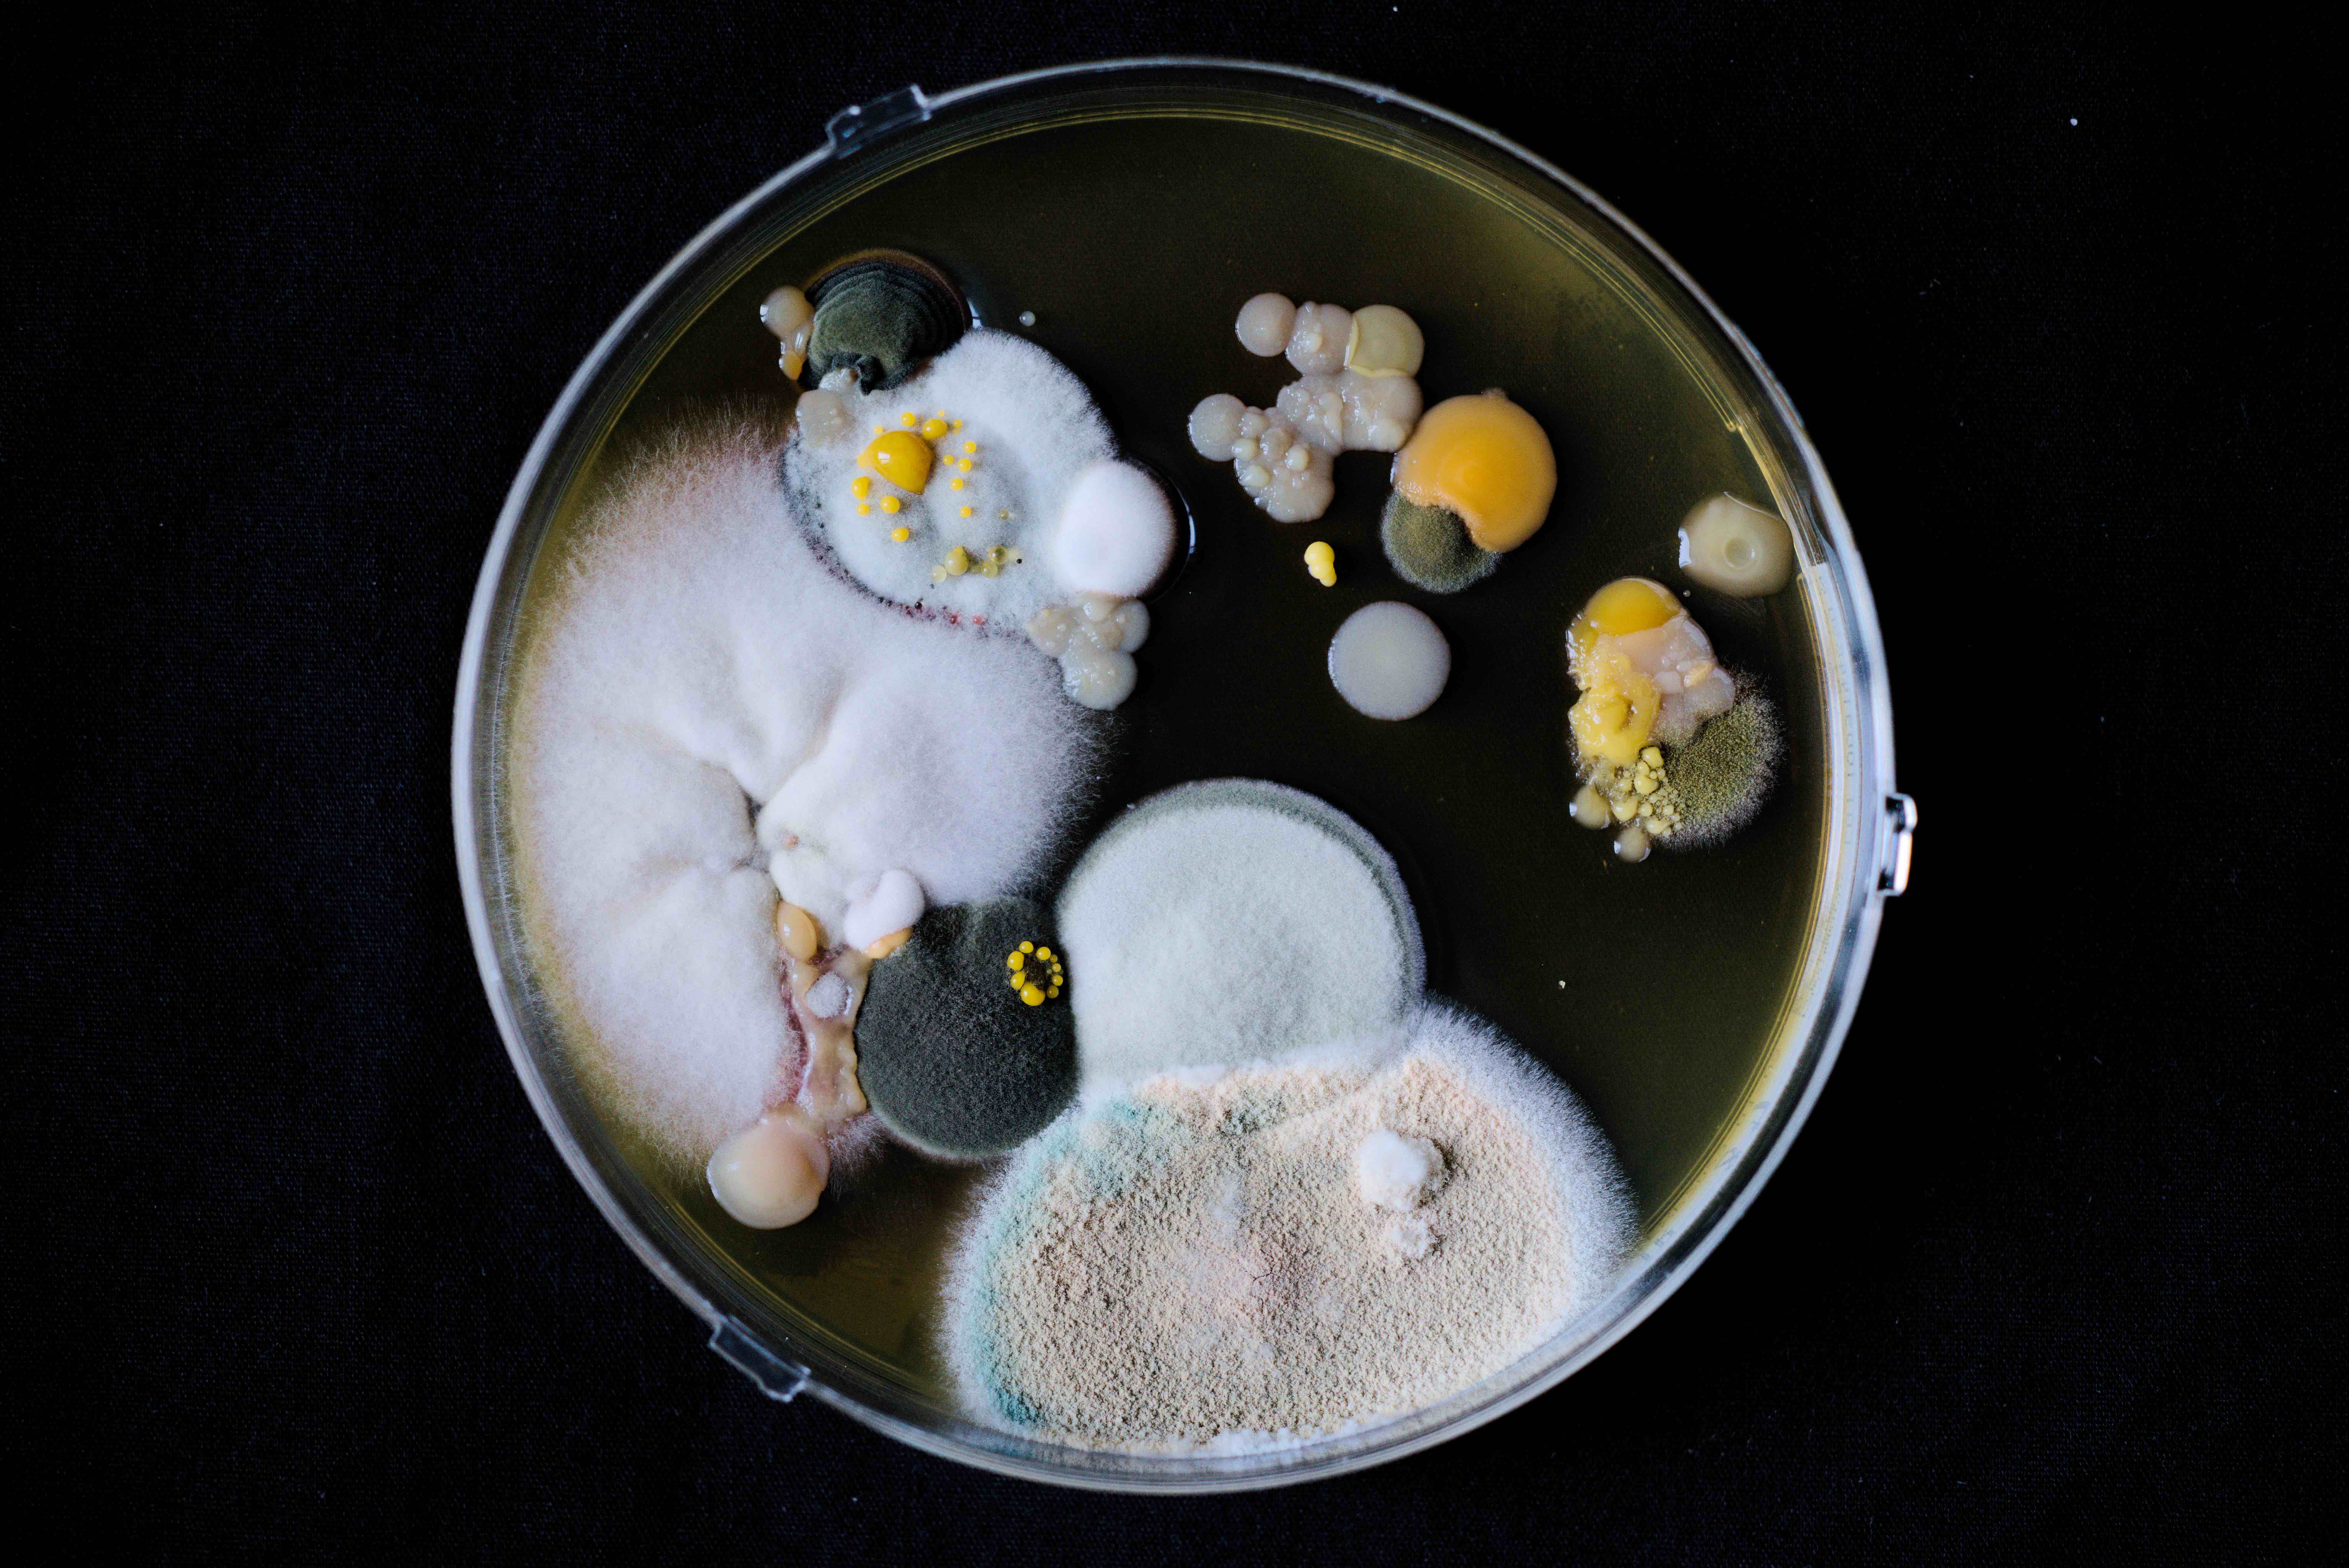

Pister l'invisible : Carnet de bord
De réflexions en piste à suivre, de rencontres en expérimentations, ils nous emmènent dans leur carnet de notes au fil de leur cheminement artistique et de pensées.
Retrouvez bientôt un objet éditorial qui reviendra sur cette exploration des vivant·es invisibles !

C’est ici que se ponctue l’aventure !
La Baleine abrite une exposition photographique et sonore où se mêlent les images d’autoportraits microbiens réalisés un an auparavant dans ce même ventre et des extrait d’entretiens réalisés avec Nidia Alvarez Rueda (chercheuse en mycologie et parasitologie médicale), Elisabeth
Cazier (maitre de conférence en microbiologie) et Frédéric Le Blay (professeur des universités en lettres anciennes) ainsi que des extraits de la sortie de résidence à Francine Vasse. Elle accueille aussi tous les matins un entre-sort où Émilie Maréchal rejoue pour quelques spectateur•ices un dialogue issu d’entretiens microphénoménologique réalisés avec le chercheur indépendant Damien Roy.
Le mini cinéma accueil lui une œuvre vidéo de dix minutes réunissant paroles de chercheur·es, film 16 mm et prises de vues microscopiques.
Une série de performances ponctue les journées dans des lieux propices à l’impromptu où dialogue corps, saxophone et paroles de chercheur•es. Moments suspendus dans le Hall Tertre, sous les arbres de la BU Sciences ou dans « l’aquarium » de Lombarderie.
C’est ici que se ponctue l’aventure, foules tremblantes parmi les foules tremblantes !





Résidence et sortie de résidence Francine Vasse
En vue de cette étape, nous réalisons en amont des entretiens sonores avec des chercheur·es dont la rencontre a particulièrement compté dans notre recherche :
- Nidia Alvarez (chercheuse en parasitologie et mycologie médicale qui nous a transmis passion et univers gloses)
- Elisabeth Cazier (maitre de conférence en microbiologie qui nous a fait partager une journée de travaux pratiques à l’IUT de Saint-Nazaire)
- Frédéric Le Blay (Professeur des Universités en lettres anciennes dont les entretiens réguliers ont irrigué toute la résidence).
L’ensemble (ou presque) des matières produites durant la résidence sont convoquées pour une création d’une performance d’une heure mêlant textes, vidéo microscopique, images 16 mm mycoses, danse et musique.



mon corps, ces jours, se transforme
à mon insu
je le sens fourmiller et pourtant
ma peau, et mes formes, restent intactes

Des nouvelles du plancton
Alors depuis l’on prend soin d’une petite communauté de Pyrocystis Fusiformis et Pyrocystis Noctiluca de manière parfaitement artisanale et affectueuse à l’aide de cocotte-minute et de filtres à café. Les finalités artistiques, elles, ont été repoussées à plus tard tant les questions éthiques, temporelles et techniques sont nombreuses…
Voici tout de même quelques images…



Deus Ex Machina
Une balade centralienneInstallation audio et numérique
Transformation de Fourier d’une image en son. Cette installation explore la transmission d’images par le son. À l’écoute du son l’image se reconstruit, révélant une dialogue invisible entre lumière, fréquence et matière.
Écho de vie
VidéoNous avons voulu mettre en avant la nature sur le campus de Centrale, à travers ses bruits que l’on entend mais qu’on ne voit pas, et l’artificialisation dont elle est victime. En effet, dans la musique, les sons proviennent tous de la nature de Centrale et sont progressivement transformés, saturés, à mesure que le chêne perd ses feuilles. Finalement, l’artificialisation est complète et désagréable : l’humain a fait disparaître la nature.
L’Art’bre
Sculpture et lampe de pocheCette œuvre représente un saule pleureur en bois, pensé comme un dispositif révélant l’invisible. À travers une anamorphose d’ombres, l’arbre devient le support d’un écosystème discret : animaux, organismes et formes de vie qui l’habitent sans être immédiatement perceptibles. En changeant de point de vue, en activant l’espace qui entoure l’arbre, des silhouettes apparaissent progressivement, comme mises en suspens entre lumière et matière. Ainsi, le mouvement et la lumière rendent visible ce qui soutient silencieusement le vivant.
Le pic-épeiche
Sculpture mécanique"C’est là le pic épeiche – « Dendrocopos Major » -
Vous distinguez enfin la créature céleste.
Certains diraient peut-être qu’il sculpte son trésor,
Il vous rappelle plus un métalleux au Hellfest
C’est bien la première fois que l’on en voit ici.
À cette réflexion-ci, vous sentez la portée.
L’invisible révélé et l’instant que voici,
Mérite que l’on s’attarde sur sa fugace beauté
Oui, qu’il vous ait fait rire ou qu’il vous ait fait peur,
Pour tous, le pic émeut. Montrons-donc qu’il existe !
Vous vous armez alors de vos mains d’ingénieur,
Mais aussi et surtout d’une certaine âme d’artiste."
Nuit blanche des chercheur·es
Un bel aboutissement de l’aventure vécue quelques semaines auparavant, toujours en complicité avec les étudiant·es qui ont pu présenter leur travail et rencontrer le public nombreux de la Nuit Blanche.




Imaginez cette fable : une espèce fait sécession. Elle déclare que les dix millions d’autres espèces de la Terre, ses parentes, sont de la « nature ».
À savoir : non pas des êtres mais des choses, non pas des acteurs mais le décor, des ressources à portée de main. Une espèce d’un côté, dix millions de l'autre, et pourtant une seule famille, un seul monde. Cette fiction est notre héritage.


Workshop à l’école centrale
Accompagné•es par des enseignant·es, chercheur·es et artistes, le but commun était de « créer un dispositif permettant de révéler de manière sensible un ou des vivants non-humains présent dans votre environnement d’étude ».
Ce dispositif pouvait être imaginaire, physique ou numérique, ou comment mettre l’ingénierie au service du vivant et questionner nos sensibilités à cet égard.
N’étant pas question de rester assis à la table, les participant·es étaient invités à explorer collectivement un espace boisé, situé en dehors du périmètre habituel des cheminements quotidiens et ponctué d’installations artistiques.
Une fois leur sujet et procédé choisi, les étudiant·es disposaient d’un accès à du matériel de captation (micros, caméra, microscopes) ainsi qu’au FabLab et ses ressources.
Ce fut une folle semaine de réflexion, de défis techniques et de travail collectif où se côtoyèrent analyse de Fourier inverse, algorithme de Griffin-Lim, initiation à la soudure, récupération et recyclage en tout genre, QR codes et sciences-fictions erdresques.
Les œuvres réalisées seront à retrouver à la Nuit Blanche des chercheur·es 2026 (Halle 6 Ouest).
Un grand bravo et merci à tous•tes les participant•es ainsi qu’à Téo Saal de Centrale Nantes, Margaux Benoist de la DCI, aux chercheur·es et enseignant·es, à l’équipe du CentraLab, et à toutes les personnes ayant participé à la réalisation de cette semaine !

Workshop Corps et micro-organismes
Telle était l’invitation à participer à un workshop corps et théâtre animé par le Collectif de la Meute (et plus particulièrement la chorégraphe Célia Rorive) au théâtre Francine Vasse en décembre 2025. Une soirée et deux journées d’expérimentations corporelles autour des matières récoltées durant la résidence Pister l’Invisible : observations et réalisations d’autoportraits microbiens, vidéos microscopiques, images 16 mm ou entretiens sonores réalisés dans la Baleine comme autant de supports à la recherche et la création de langages non verbaux (mais aussi parfois bien bavards).
L’atelier était accompagné d’un ingénieur du son et d’un ingénieur lumière du théâtre afin d’offrir des possibilités de mise-en-scène qu’offre le plateau d’un tel lieu et ce fut l’occasion d’une très belle restitution.
Un grand merci à toute l’équipe de Francine Vasse pour leur accueil !
Nous les retrouverons au mois de mars pour deux semaines de résidence et une sortie publique le 12 mars à 19h.




Extraits choisis
Mais, une fois arrivé à destination, je fus accueilli par des milliards de bactéries qui se bataillaient inlassablement. Ils formaient presque une nuée si opaque qu’elle obstruait la vue de n’importe où dans l’estomac. Un détail attira mon attention, une sorte de forteresse inconnue se dressait fièrement dans ce champ de bataille. Elle revêtait des briques peintes d’un noir d'onyx, des toits d’un rouge carmin sanglant dont le bout se conclut par une longue pique acérée.
Ludvig
Je fais même pas 2 mm, rouge ou violet, je suis un petit bâtonnet un peu allongé et un peu tordu comme un cheetos soufflé au fromage.
Ou quelquefois tout aussi rond qu’une boulette de viande et un peu plus soyeux et doux.
Ensemble, nous faisons un tout un peu plus grand, 10 milliards ou même 38 billions quand on nous dénombre
Marie-Alie
J’ai grandi entre deux univers. Je suis née d’un chaos continental, de la violence de la tectonique, de la terre qui vole en éclats et qui s’effrite. Je suis la montagne.
Autour de moi, mes sœurs, créées dans la même souffrance et par les mêmes lois. Chaque siècle, je grandis, chaque millénaire, je vieillis.
Je ne suis pas seule. Le vent me souffle ses poèmes enlaçant, et la lune la nuit me susurre ses syllabes. Mais surtout, je ne suis pas qu’une. À travers mes entrailles, et sur mon paysage vivent tous ces êtres innombrables et sauvages. Je suis l’arbre à la lisière du bois, le ruisseau qui cascade tout en bas, la grotte sombre cachée sous les roches, et la terre meuble sous les coussinets des prédateurs.
Surtout, je suis ce petit être invisible, et presque imperceptible, minuscule pour moi et qui pourtant fait entendre sa voix. Je ressens cet être caché dans les bois, sur un cyprès, sur une branche.
Une cellule de lichen.
Margaux
Iel est là, sur l’algue.
Photosynthèse.
Nourriture de ses hôtes.
Créateur de falaise.
Entre mer et ciel. Multiple.
Plus bas, un autre.
Une goutte dans l’eau.
Être liquide.
Seul, puis par milliers.
Effervescence aveuglante.
Mort, vie.
Se déplace vers le Nord.
Annaëlle
Atelier d'écriture
Au mois d’octobre 2025 le Collectif De la Meute invitait étudiant·es et personnel·les de l’université pour un laboratoire d’écriture créative mené par Émilie Maréchal visant à convoquer la fiction pour mieux raconter et questionner nos rapports aux vivants invisibles de nos vies.“ Dis-moi comment tu racontes, je te dirai à la construction de quoi tu participes.” Isabelle Stengers
Loti·es dans l’espace Laennec de la BU santé, sa vue sur les toits et sa moquette rouge, une dizaine de participant·es se sont réuni·es trois soirées et une après-midi afin de travailler à de courts textes et une mise en voix des épreuves.



Festival de rentrée et Boom des micro-organismes
Rentrée 2025.
Passer de l’observation à l’expérience. Quitter l’œilleton des microscopes et les doigts des géloses pour tenter des formes de sensibilités directes. Est-il possible de se sentir pluriels·les, peuplés·es ou symbiotiques ?
À l’occasion du Festival de Rentrée de Nantes Université, nous partons sur la création d’une Boum des Micro-organismes.
Arrivés à Tertre, nous avons deux jours au Pole Étudiant pour mettre en scène la Boum à l’intérieur de la Baleine.
L’intérieur de la Baleine est désormais un ventre sombre où il faut enlever ses chaussures. Une boule à facette, des cliquetis sonores organiques semblant provenir du sol et de la carcasse, des images mouvantes et une invitation d’une dizaine de minutes à se sentir grouiller à plusieurs, portés par Célia Rorive et Damien Brassard. Plus les heures passent, plus la fête s’installe et, force est de constater, qu’il est plus facile de s’évader dans la Boum à l’heure de la nuit qu’à celle du goûter.
Nous retiendrons les chaussures attendant aux pieds de la Baleine, la chaleur du ventre quand on y danse et la suspension du temps.

Préparation de la boum
Extraits (non exhaustifs) d’un compte rendu d’entretien :
« Il y a un peu cette chose-là de véritablement changer d’échelle et de devenir un peu… à la hauteur de quelque chose qui est normalement petit mais qui devient gros et qui épouse la forme de mon visage » (A.7.2) ;
« C'est un peu gluant, un peu spongieux [...] des aimants qui se repoussent » (A.66.1-2) ;
« bouger vite ou pas selon l'épaisseur »
Description synthétique : L’expérience se transforme par un changement d’échelle : le sujet se sent devenir petit, adoptant une perspective non humaine. Une transformation corporelle et sensorielle s’amorce.

Entrer dans le ventre d’une baleine.
Musiques, danses, images et mouvements immergent dans un univers sensoriel inédit.
Porté par les flux, les corps devinent le mouvement des micro-organismes qui circulent sur, sous la peau. L’eau intérieure se fluidifie à mesure que la danse s’installe. Le corps devient un genre de littoral — une rencontre.
Soutenir le regard des tardigrades.
Discerner l’émoi des levures.
Deviner la danse des acariens nichés dans les sourcils.
Il s’agit de refaire connaissance car dans les entrailles du cétacé
« Je est un Nous »







Workshop à l'IUT de Nantes
Une résidence en parallèle
Ce workshop fut l’occasion d’une résidence parallèle du reste de l’équipe dans l’idée d’ateliers croisés. Ambiance industrielle où se sont côtoyés micro-organismes, compagnons•nes du devoir, découpeuses à jet d’eau et projections sur sculptures dans les va-et-vient des chalumeaux et odeurs de soudures.Il s’agissait d’une occasion de faire atelier ensemble et que les activités de chacun•e nourrissent celles des voisins•es. S’installer quelque part durant quelques jours et avoir l’espace d’expérimenter, de bricoler ou de travailler à la table dans la porosité des pratiques.
Ce fut l’occasion de se replonger dans les entretiens réalisés dans la caravane Baleine à l’occasion des immersions du mois de mars sur les campus de Lombarderie, Tertres et Heinlex. Retour sur ces histoires parfois loufoques, souvent intimes et riches de récits.
Recherches autour des auto-portraits en gélose
Ce fut d’ailleurs aussi l'occasion de finaliser les prises de vues des autoportraits croisés aux entretiens : ceux des flores cutanées des personnes rencontrées.Cette part du Nous avec qui nous vivons et qui grouille bien au-delà des moments manifestes. La part des autres rencontrés qu'il nous reste aussi.
Dans cette optique, la résidence à Carquefou permis aussi de tenter de nouveaux formats d’autoportraits gélosés, plus libres, moins contraint par la boite de pétri. Moins clinique aussi. Il s’agissait de refondre des géloses périmées, sans autoclave, afin de pouvoir effectuer des empreintes de volumes tels qu’un visage entier.
[NB : une canicule est plus favorable à la culture de micro-organismes qu’une caravane sous la pluie…].
Micro-organismes sur film
Quitte à être dans les casseroles et l’agar-agar (principal composé d’une gélose) nous avons pu reprendre une partie de la démarche initiée à l’occasion du workshop 16mm qui eut lieu à Mire au mois de décembre. Grâce à l’aide de Julien Grison (responsable d’atelier à l’IUT) nous avons fabriqué un prototype de moule à coulée de gélose sur film 16mm afin d’imaginer des cultures de micro-organismes sur film de manière différente des techniques jusque-là utilisées.Merci infiniment à toute l’équipe de l’IUT qui nous a reçu avec une malice et créativité superbe.


Série 13.18, étape de travail de recherche plastique







Extraits du carnet de Laurent Cadhilac
- Pour 37.5 ml, 1 boîte de Petri;
- 37 ml eau
- 0.7g agar-agar
- 0.7g sucre de malt (extrait de malt)
- 0.15g de substrat final (sciure de bois, paille en poudre…)
- 0.1g levure
- 0.06g farine (seigle/blé)
- (facultatif) 0.04g peptone
Test PÉTRI//gel de paraffine 3,3%
Pas très concluant, trop opaque, on ne voit plus vraiment le dessin intérieur dans la profondeur de 3,5 cm pour 18 cm de diamètre.Tests pour essayer de stabiliser dans le temps et la température ces disques transparents, les PÉTRI (sus nommés) et en profiter à chaque fois pour rapidement explorer des matières, des graphismes, dans les paysages intérieurs…
La gélatine (de bœuf 200 bloom unité de gélification) c’est différent dans le résultat que l’agar. Plus jaune, très transparent, donc pas facile de donner un rapport de profondeur aux images. Mais ça reste très intéressant à mettre dans la bourriche.
J’ai aussi cherché avec la piste eau libre – eau prisonnière (cf Elisabeth Cazier à propos des bonbons Haribo !) et c’est prometteur. En ajoutant une part de sucre (je suis pour l’instant entre 20 et 25 % de la masse d’eau) la gélification se passe très bien. À voir si ça prolonge son état (voir ça élève la température de conservation) ?
Introduction aussi de la glycérine (composé organique qui peut se diluer dans l’eau et supporte bien la chaleur, qui est hygroscopique… permet de retenir l’eau )… je pense que c’est une piste prometteuse aussi.
J’attends de voir avec le temps comment les tests évoluent.
Bien noter tous les protocoles de test, les mises en œuvres et les bonnes petites combines.

J'ai fait le camembert de mon microbiote. – JC


Immersions
Trois semaines, trois campus à la rencontre de celles et ceux qui les habitent.
Retour à Lombarderie où les soupes avaient été servies puis dans la cour de l'IUT de Saint Nazaire et enfin Tertre.
Un laboratoire mobile pour chercher où bon nous semble et recueillir des histoires manifestes ou ténues de vie invisibles ou presque. Une baleine-salon pour évoquer ce qui vit sur nous, en nous et ce que nous sommes. Comment penser ces insectes microbiens qui nous peuplent et sans qui un corps se meurt ? « Je est un Nous » répétons-nous souvent alors.
La tisane au gingembre est un premier geste pour initier la rencontre et ouvrir le chemin des récits.
Un magnétophone à cassette posé sur la table du salon, quelques microscopes et une petite serre pour y faire pousser les portraits de microbiotes recueillis, qui côtoieront les autoportraits des humains hôtes.
Choisir une partie de son corps pour dresser le portrait de ceux qui s'y trouvent. Paupières, talons, pommettes ou cheveux. Avec qui vis-je ?
Nous avons recueilli une centaine de portraits, plus ou moins détaillés, plus ou moins fouillés ou digressifs, en fonction des horaires du RU, de la file d'attente et de ce qu'il y avait à dire à ce moment-là.
Des histoires d'odeurs, de senteur, de maladies, de corps qui se rencontrent, de ce qui révulse, de violences, de changement d'échelle d'un point de vue géométrique, de l'odeur des cailloux, de flores désirées, d'insectes dont il faut se débarrasser frénétiquement, du dégout de cette vie sur soi, de la terre qui enivre, de la peur de mourir, des humains et des autres.
Merci à l'ensemble des personnes qui sont venues à notre rencontre et qui ont accepté de déposer leurs récits ainsi qu'à celles et ceux qui ont concouru à la mise en œuvre de cette résidence dans ses plus ou moins grands détails.


Nuit blanche des chercheur.es
Un labo mobile de cinéma est monté, petite grotte pour quelques personnes, où se manipulent et se révèlent des empreintes de champignons et autres organismes sur les émulsions du film 16 mm et du papier photo.
Les films et tirages sèchent parmi les apparitions sur les écrans de papier japonais suspendu et le flot ininterrompu de visiteur·ices.
Le laboratoire Isomer (avec la complicité d'Olivier Grovel et de ses collègues) nous a préparé quelques cultures de champignons marins pour l'occasion, avec la consigne de ne surtout pas ouvrir les boites (que nous avons respecté). Est-il possible de mettre en culture ces mêmes champignons sur d'autres surfaces que des boites de gélose ?
« Je suis un genre de littoral » va-et-vient sur une colonne.
Au-dehors, résonnent des robots, visualiseurs de particules invisibles et foodtruck sans truck.
Un grand merci à Margaux et l'équipe des médiatrices pour leur renfort essentiel.
« Nous sommes tous·tes le fruit d'une indigestion » nous dit Donna Haraway.





En vue d'une résidence à l'IUT de Carquefou
Retour avec quelques moteurs et un oscilloscope qui nous révèlera une image du son de la photosynthèse sous-marine.
L'émulation des ateliers nous donne l'envie d'adjoindre une résidence de production aux côtés du workshop de Laurent...




Microbiologie : initiation aux travaux pratiques avec Elisabeth Cazier
Nous retrouvons l'énergie d'Elisabeth pour une journée sur paillasse à l'IUT de Saint-Nazaire dans le département génie Chimique Génie des procédés.
Notre demande avait été la suivante :
- nous familiariser avec l'utilisation d'un microscope jusqu'au x100 (et la question de l'huile pour cette valeur)
- tenter de voir des bactéries se trouvant sur nos peaux ou dans nos bouches
- tenter de voir un tardigrade
- tenter de voir des champignons/moisissures
- tenter de voir des diatomées (cf le TP3)
- tenter de voir des micro-algues et plancton d'eau douce/de mer
Il fallait au préalable s'être plongé dans un cours d'enseignement de première année où nous apprenions par exemple qu'un flagelle pouvait être de type :
- Monotriche (unipolaire) – Vibrio cholerae
- Lophotriche (unipolaire) –Pseudomonas aeruginosa
- Amphitriche (bipolaire) – Campylobacter
- Péritriche – E. Coli
Manière de dire que ce ne fut pas facile...
Et enfin : Verre cassé, pipette, bec bunzen et tardigrade. Mettre ou non des bulles entre lames et lamelles, voir les bords, « est-ce un travelling ? », chercher ce qui se meut, « mais, j'avais donc un truc qui bougeait dans ma bouche ».
Vivants inertes, vivants mouvants.
Nous ne savions pas qu'en frottant une huitre avec une brosse à dent, nous tomberions sur des diatomées.
Ils nous faut donc bien un microscope.
Un immense merci à Elisabeth pour le partage de toutes ces connaissances et gestes qui sont venus enfin répondre à tant de questions et d'envies.



14/12 | Workshop 16mm
Cinéma et organismes vivants – Acariens et champignons sur film 16mm.
Neuf étudiant•es se sont initié•es aux pratiques du cinéma argentique dans le laboratoire artisanal de l'association Mire et, plus particulièrement, à créer des images animées en collaborant avec des organismes vivants peuplant discrètement nos environnements.
Deux jours dans le rouge et les moisissures à fabriquer des images par le geste et avec des rhizomes.
Sous l'oeil avisé de Carole Thibaud





Décembre | En atelier
Saint Etienne de Montluc- Atelier de Laurent Cadilhac
Appropriation expérimentale de l'univers de gélose, utilisée en biologie.Sculpture, formes et représentations.
Cuisine, moisissure et changement d'échelle...
Travail en cours...
Une boîte de Pétri est une boîte cylindrique transparente peu profonde, en verre ou en plastique, munie d'un couvercle. Facilement manipulable, empilable et peu coûteuse, elle est utilisée en microbiologie pour la mise en culture de micro-organismes, de bactéries ou de cellules d'organismes supérieurs.



9-11/12 | Premières rencontres
Oignon, patate, choux-fleur, gingembre, eau et crème.
Une soupe contre une histoire.
"J'avais beaucoup de poux et à l'époque, je rêvais que des bêtes invisibles me rentraient dans le crâne."

" Quand j'étais petit, j'avais 4 ans et j'ai eu une méningite...mais elle n'était que virale et non bactérienne alors ça va, je ne suis pas mort... ."

"C'est que nous ne connaissons que des micro-organismes pas très sympas..."

"C'est fou de se dire qu'il y a dans l'air tant de choses que l'on ne soupçonne pas, alors qu'en fait, des trucs vivants il y en a partout."
"Le chant des baleines, si proche et invisible sous moi."

"Une mycose se nourrit de ce que tu manges, comme la bière par exemple..."
"Mon bide est en vrac, mais c'est à cause de ma vésicule biliaire, pas à cause de trucs vivants je crois..."

Visite de Collections
BU Lettre et ses archives // Collection d'Herbiers // Collection d'Alguiers // Droguerie en pharma // Collection de médecine et d'outils optiques.
Lichens sur cailloux, algues séchées innombrables, lentilles bien rangées, matériel de cinéma dormant qui donne les yeux qui brillent, « c'est quoi ça ? ».
Attention, ne pas se perdre dans tous ces mondes et leurs histoires...

Rencontre avec Elisabeth Cazier
Micro-organisme et travaux pratiques
Quand ça colore l'ADN c'est que c'est cancérigène.Ne pas oublier les lamelles, les lames, le pshit-pshit et de spray nettoyant (éthanol).
Les membres de l'Expédition Franklin sont tous morts, du saturnisme et du botulisme...
Nous nous revoyons vite, notamment pour une journée de travaux pratiques sur paillasse : microscopes, boîte de pétri, kombucha et mycélium... hâte.
Rencontre avec Jordan Prieto
Micro-biologiste, spécialiste des microbiotes humains. Discussion libre et passionnante.
Il est possible de modéliser le microbiote moyen d'un•e parisien•ne// Royaume ? ... ? genre ? espèce ? souche //
Tout ce qui est exposé de nos corps est colonisable.
T'as pas les enzymes.
Les humains sont avant-tout microbiens / Sans eux, la mort.
Microbiote : ensemble des micro-organismes — bactéries, microchampignons, protistes — vivant dans un environnement spécifique chez un hôte ou une matière (d'origine animale ou végétale). Ces micro-organismes peuvent être présents sans impact sur leur hôte (commensalisme) ou entrer en interaction étroite avec lui (mutualisme, parasitisme non létal).
Retour en cours avec Frédéric Le Blay
Philosophe et historien des sciences, il travaille notamment sur les représentations des vivants par les humains aux temps antiques...
On écoute et on gratte le papier assis parmi les étudiants du master Humanités Environnementales. « Le mythe a été sauvé par l'allégorie alors qu'il aurait dû disparaître, éliminé par les historiens ». Puis l'on écoute Pline le jeune évoquer les « êtres animés », et comment alors l'éléphant était l'être le plus proche d'un être humain...


Rencontre avec Nidia Alvarez Rueda
Première rencontre avec une chercheuse après la phase de familiarisation. Département de Parasitologie et Mycologie Médicale, enfin accès à un labo, c'est emballant.
Odeurs étranges, pièces interdites et collection de loupes d'études.Piste : Il est possible de dévoiler à nos yeux les vivants qui se trouvent sur nos corps à l'aide de mise en culture sur gélose...
Visite et rencontre avec l'équipe du Gepea et d'Algosolis
Mondes marins minuscules et bioréacteurs.
"Est-il possible de mettre en culture du plancton bioluminescent ? – Oui...nous avons d'ailleurs un vieux bio-réacteur qui traîne..."



Début de la résidence
Audition, jury, plan, chronomètre.
05/04/24
« Vous l'avez »
Joie & Oulala.
Puis c'est le début.
Bonjours, sourires et « Qui est-ce ? », cafés et RU pour commencer.
Visite au pas de courses des campus, présentation du projet aux directeur·ices d'Unité de Recherche et représentations du projet.
Cours d'acronymes intensif, début d'écritures, repérages et premières visites et rencontres.






